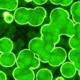

Spirulina – Energie aus der Urzeit: Wie die Mikroalge Ihre Mitochondrien stärkt
Wussten Sie, dass Spirulina sowohl von der NASA als auch von der Europäischen Weltraumorganisation (ESA) als Hauptnahrungsmittel für Langzeitmissionen eingesetzt wird?
Das hat gute Gründe – und sie reichen weit über ihren Ruf als „Superfood“ hinaus. Spirulina wirkt dort, wo Energie entsteht: in den Mitochondrien, den Kraftwerken unserer Zellen.
Was Spirulina wirklich ist
Spirulina wird oft als „Blaualge“ bezeichnet, ist biologisch jedoch ein Cyanobakterium – eines der ältesten Lebewesen der Erde. Es betreibt Photosynthese, bindet Lichtenergie und produziert Sauerstoff. Zwei Arten sind für die Nahrungsergänzung relevant: Arthrospira platensis und Arthrospira maxima. Beide wachsen in alkalischen Seen und gedeihen in Süß- wie Meerwasser.
Obwohl Spirulina bakterieller Natur ist, enthält sie komplexe Eiweiße, Pigmente und Fettsäuren, die man sonst nur in höher entwickelten Organismen findet – ein biochemischer Schatz aus der Urzeit.
Nährstoffdichte, die ihresgleichen sucht
Spirulina besteht zu über 60 % aus Eiweiß – und liefert alle essentiellen Aminosäuren, wenn auch mit geringeren Mengen an Methionin, Cystein und Lysin als tierische Proteine. Dennoch liegt ihre biologische Wertigkeit deutlich über der pflanzlicher Proteine.
Dazu kommen:
- Essentielle Fettsäuren: Gamma-Linolensäure, Linolsäure, Alpha-Linolensäure, EPA, DHA, Arachidonsäure.
- Vitamine: A, B1, B2, B3, B6, B9, B12 (umstritten bioverfügbar), C, D und E.
- Mineralien: Eisen, Magnesium, Kalium, Zink, Mangan, Chrom, Selen u.v.m.
- Pigmente: Chlorophyll, Beta-Carotin, Xanthophyll und das charakteristische Phycocyanin – eines der stärksten bekannten Antioxidantien.
Ein kleiner „Schmutzfleck“ taucht allerdings beim Vitamin B12 auf, denn die Bioverfügbarkeit dieses Vitamins aus Spirulina für den menschlichen Organismus ist umstritten. Bei den Mineralien, die der Spirulina-Esser erwarten kann, tut sich ebenfalls ein reichhaltiges Programm auf: Kalium ist besonders reichhaltig vertreten, aber auch Kalzium, Chrom, Kupfer, Eisen, Magnesium, Mangan, Phosphor, Selen, Natrium und Zink sind ausreichend vorhanden.
Darüber hinaus enthält es eine Reihe von Pigmenten wie Chlorophyll-a, Xanthophyll, Beta-Carotin usw. Obwohl es nicht so viel Chlorophyll enthält wie Chlorella pyrenoidosa, ist sein Chlorophyll-Gehalt mehr als ausreichend.
Noch ein schwarzer Fleck: Da Spirulina alle essentiellen Aminosäuren enthält, enthält es auch Phenylalanin. Leute mit Phenylketonurie sind nicht in der Lage, diese Aminosäure zu verarbeiten, so dass dieses sich im Gehirn anreichern kann und zu Langzeitschäden führen kann. Von daher ist bei diesen Leuten ein Spirulina Einsatz mit Vorsicht zu genießen.
Übrigens: Wenn Sie solche Informationen interessieren, dann fordern Sie unbedingt meinen Heilpflanzen-Newsletter dazu an. Darin geht es im Wesentlichen um Heilpflanzen, aber auch um Bachblüten oder Homöopathische Mittel:
Energie auf Zellebene: Mitochondriale Wirkung von Spirulina
Das eigentliche Problem: Energiemangel durch Mitochondrienerschöpfung
Unsere Mitochondrien erzeugen das ATP – also die Energie, die jede Bewegung, jeden Gedanken und jeden Herzschlag möglich macht.
Mit dem Alter, oxidativem Stress, Bewegungsmangel oder Fehlernährung sinkt ihre Effizienz. Die Folge: chronische Müdigkeit, Muskelschwäche, mentale Erschöpfung.
Studien deuten darauf hin, dass bis zu 90 % der Bevölkerung eine Form mitochondrialer Dysfunktion aufweist. Das zeigt sich nicht als Krankheit, sondern als anhaltende Energielosigkeit. Koffein hilft da nur kurzfristig – es übertönt das Problem, anstatt es zu lösen.
Spirulina als mitochondrialer Regenerator
Spirulina greift an zwei zentralen Punkten ein:
A) Aktivierung der Fettverbrennung (CPT1-Mechanismus)
Fett ist der hochwertigste und ausdauerndste Brennstoff des Körpers.
Damit Fett in Energie umgewandelt werden kann, muss es in die Mitochondrien transportiert werden – über ein Schlüsselenzym namens Carnitin-Palmitoyl-Transferase 1 (CPT1).
Mit zunehmendem Alter oder bei Insulinresistenz funktioniert dieser „Torwächter“ schlechter. Das Fett bleibt gewissermaßen im Tank stecken.
Spirulina aktiviert CPT1 und öffnet die „Kraftstoffleitung“ wieder – mehr Fett gelangt in die Mitochondrien, wo es effizient zu Energie verbrannt wird.
Das erhöht die Fettverbrennung und Ausdauer und stabilisiert den Energiefluss über Stunden hinweg.
B) Zellschutz und Antioxidationswirkung
Das blaue Pigment Phycocyanin wirkt als natürlicher Entzündungshemmer und Antioxidans. Es erhöht die körpereigene Produktion von Glutathion und Superoxiddismutase (SOD) – zentrale Enzyme der zellulären Entgiftung. Diese schützen die Mitochondrien vor oxidativem Stress, der durch Energieproduktion selbst entsteht.
Darüber hinaus unterstützt Spirulina den Abbau von Laktat (Milchsäure) – der „Muskelbrenner“ beim Sport wird schneller recycelt, was Erholung und Leistungsfähigkeit verbessert.
Nachgewiesene gesundheitliche Effekte
Die Liste der Studien ist lang. Auswahl der wichtigsten Befunde:
- Antiviral: Spirulina hemmt die HIV-Replikation in menschlichen T-Lymphozyten (Ayehunie et al., JAIDS, 1998).
- Neuroprotektiv: Schutz vor eisenbedingtem oxidativem Stress in Nervenzellen (Barmejo-Bescós et al., Toxicology in Vitro, 2008).
- Herzschutz: Spirulina vermindert Chemotherapie-induzierte Herzschäden, ohne die Wirkung der Medikamente zu mindern (Khan et al., Phytotherapy Research, 2005).
- Gehirn & Gedächtnis: Reduktion von Schlaganfallfolgen und altersbedingtem Gedächtnisverlust (Wang et al., 2005; Gemma et al., 2002).
- Allergien & Entzündungen: Deutliche Verbesserung bei allergischer Rhinitis, Reduktion entzündlicher Zytokine (Cingi et al., Eur. Arch. ORL, 2008).
- Lipide & Gefäße: Verbesserung des LDL/HDL-Verhältnisses bei Senioren (Park et al., Ann. Nutr. Metab., 2008).
- Sport & Regeneration: Geringere Muskelabbau-Marker, höhere Ausdauer (Lu et al., Eur. J. Appl. Physiol., 2006; Kalafati et al., Med. Sci. Sports Exerc., 2010).
Anwendung, Dosierung und Qualität
- Dosierung: 2–3 g täglich reichen zur Basisversorgung; Sportler nutzen 5–7 g.
- Zeitpunkt: Ideal vor leichter körperlicher Aktivität – Spaziergang, Gartenarbeit, moderates Training.
- Einnahmeform: Pulver oder Tablette; Pulver hat den Vorteil, dass es unverarbeitet ist.
- Qualität: Entscheidend ist Reinheit. Billige Ware kann Schwermetalle enthalten.
→ Empfehlenswert sind geprüfte Produkte mit Herkunftsnachweis (Hawaii, Indien, Kalifornien oder kontrollierte Indoor-Kulturen).
Spirulina und Methylenblau – Synergie für die Zellenergie
Methylenblau (MB) ist ein synthetischer Elektronentransporter, der geschädigte Mitochondrien wieder in Gang bringen kann.
Spirulina und MB wirken komplementär:
- Spirulina öffnet die „Fettzufuhr“ über CPT1.
- MB verbessert die Energieverarbeitung innerhalb der Mitochondrien.
Beide reduzieren oxidativen Stress – Spirulina über Phycocyanin, MB über direkte Elektronenweitergabe. In niedrigen Dosen (4–8 mg MB) kann die Kombination eine synergetische Energie- und Regenerationswirkung entfalten. Auch hier gilt: Nur pharmazeutisch reine Substanzen verwenden.
Fazit: Zellenergie statt Koffein-Kick
Spirulina ist kein Wundermittel, aber ein zellulärer Reparaturtrupp. Es verbessert die Fettverbrennung, stärkt die Mitochondrien, schützt vor oxidativem Stress – und liefert Energie, die nicht verpufft. Wer statt des nächsten Koffein-Schubs lieber auf echte Energiegewinnung setzt, findet in Spirulina einen der wirksamsten natürlichen Verbündeten.
weitere Algen-Arten und Gattungen:
Afa Algen – Blasentang – Blaugrüne Algen – Chlorella Algen – Chlorella vulgaris – Chlorella Pyrenoidosa – Dunaliela salina – Kelp Algen – Klamath Algen – Kombu Algen – Nori Algen – Wakame Algen
Übrigens: Wenn Sie solche Informationen interessieren, dann fordern Sie unbedingt meinen Praxis-Newsletter mit den „5 Wundermitteln“ an:
Kleine Anmerkung: Die Sache mit den „5 Wundermitteln“ ist mit Abstand der beliebteste Newsletter, den meine Patienten gerne lesen…